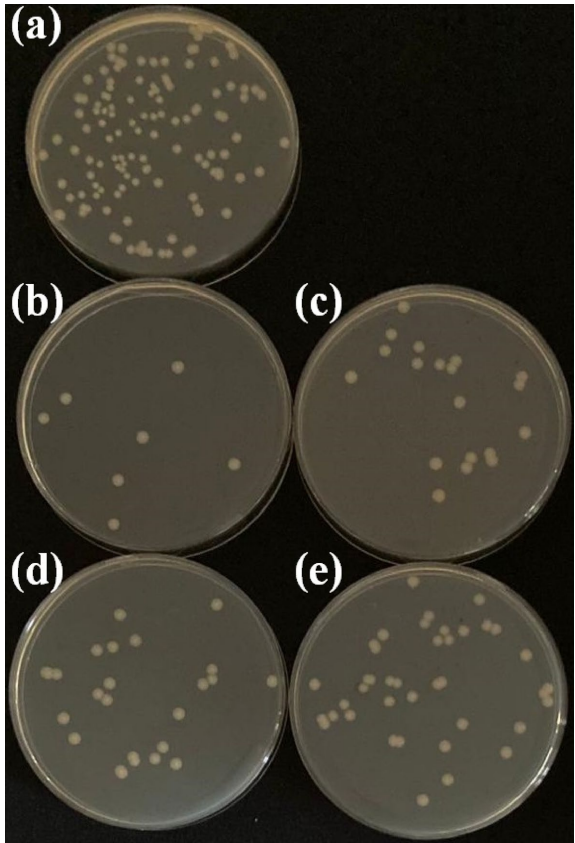
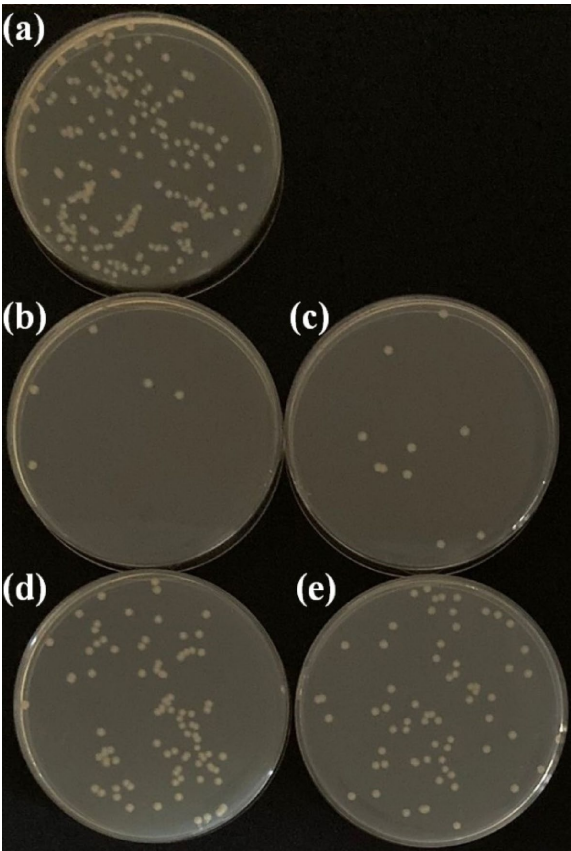

-
生物通官微
陪你抓住生命科技
跳动的脉搏
低电压阳极氧化TiO2层在Ti45Nb合金表面的润湿性与抗菌性能研究及其植入应用前景
【字体: 大 中 小 】 时间:2025年09月27日 来源:Scientific Reports 3.9
编辑推荐:
本研究针对植入体表面细菌感染和骨整合不足的问题,通过低电压阳极氧化(AO)技术在Ti45Nb合金表面构建TiO2涂层。研究发现25V电压下制备的涂层对大肠杆菌(E. coli)和金黄色葡萄球菌(S. aureus)的抑制率分别达93.3%和96.7%,且亲水性随电压升高而增强。该研究为开发兼具优异抗菌性能和生物相容性的钛合金植入体提供了新策略。

生物通微信公众号
知名企业招聘